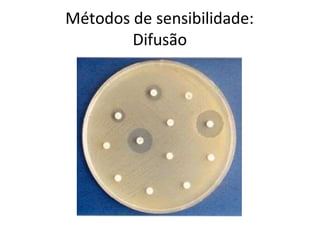
Métodos de sensibilidade:
Difusão
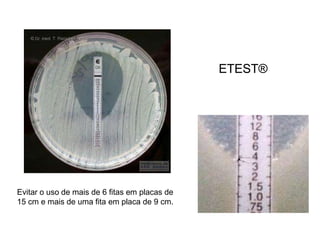
Evitar o uso de mais de 6 fitas em placas de
15 cm e mais de uma fita em placa de 9 cm.
ETEST®
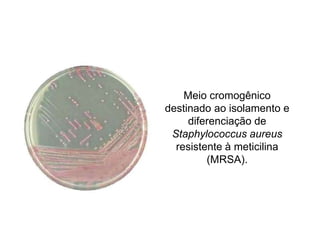
Meio cromogênico
destinado ao isolamento e
diferenciação de
Staphylococcus aureus
resistente à meticilina
(MRSA).

O documento descreve os principais métodos para realização de antibiograma, incluindo difusão em disco, diluição em caldo e testes automatizados. É destacada a importância de padronizar a técnica para obter resultados precisos sobre a sensibilidade de microrganismos a antibióticos.

![Escala de McFarland
• Padrão de turvação utilizado para determinar a
intensidade de multiplicação bacteriana em meios de
culturas líquidos
• O grau de turvação indica a [ ] das bactérias.
• O método consiste em uma escala de onze tubos 0,5
a 10 com diferentes quantidades de cloreto de bário
e ácido sulfúrico para se obter diferentes
concentrações de sulfato de bário.](https://image.slidesharecdn.com/antibiograma-230405171511-6f539919/85/ANTIBIOGRAMA-pptx-8-320.jpg)